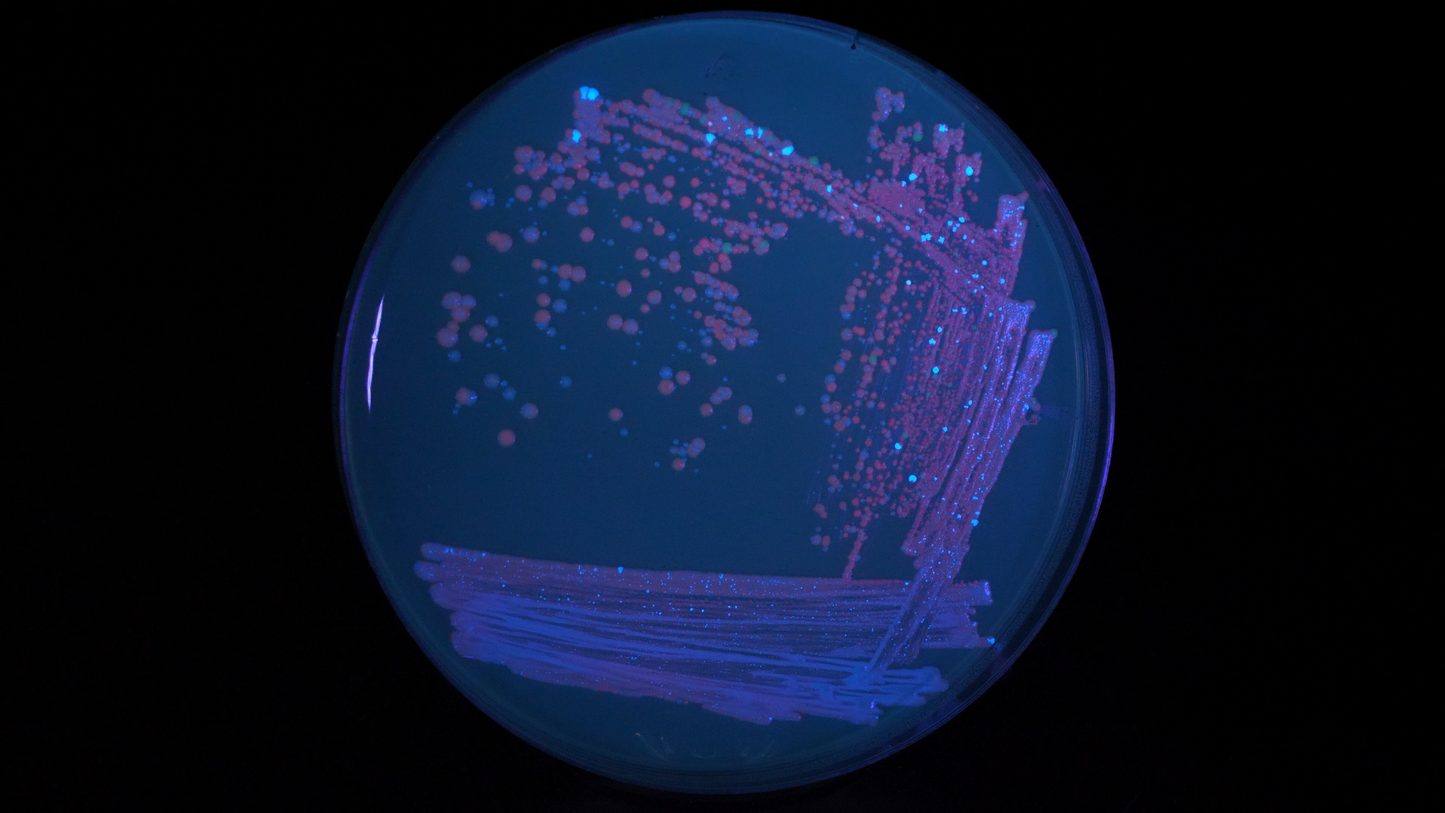
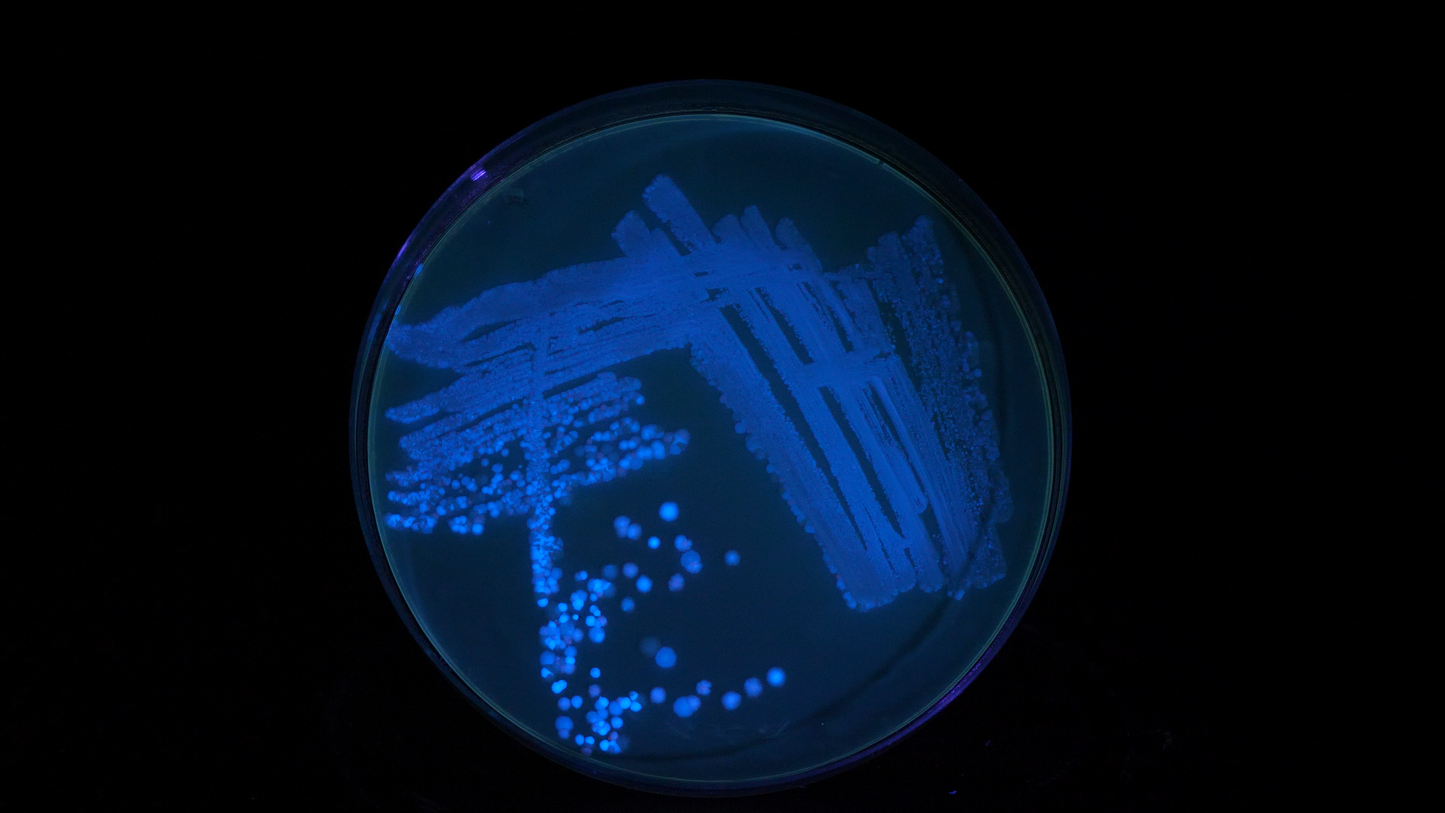
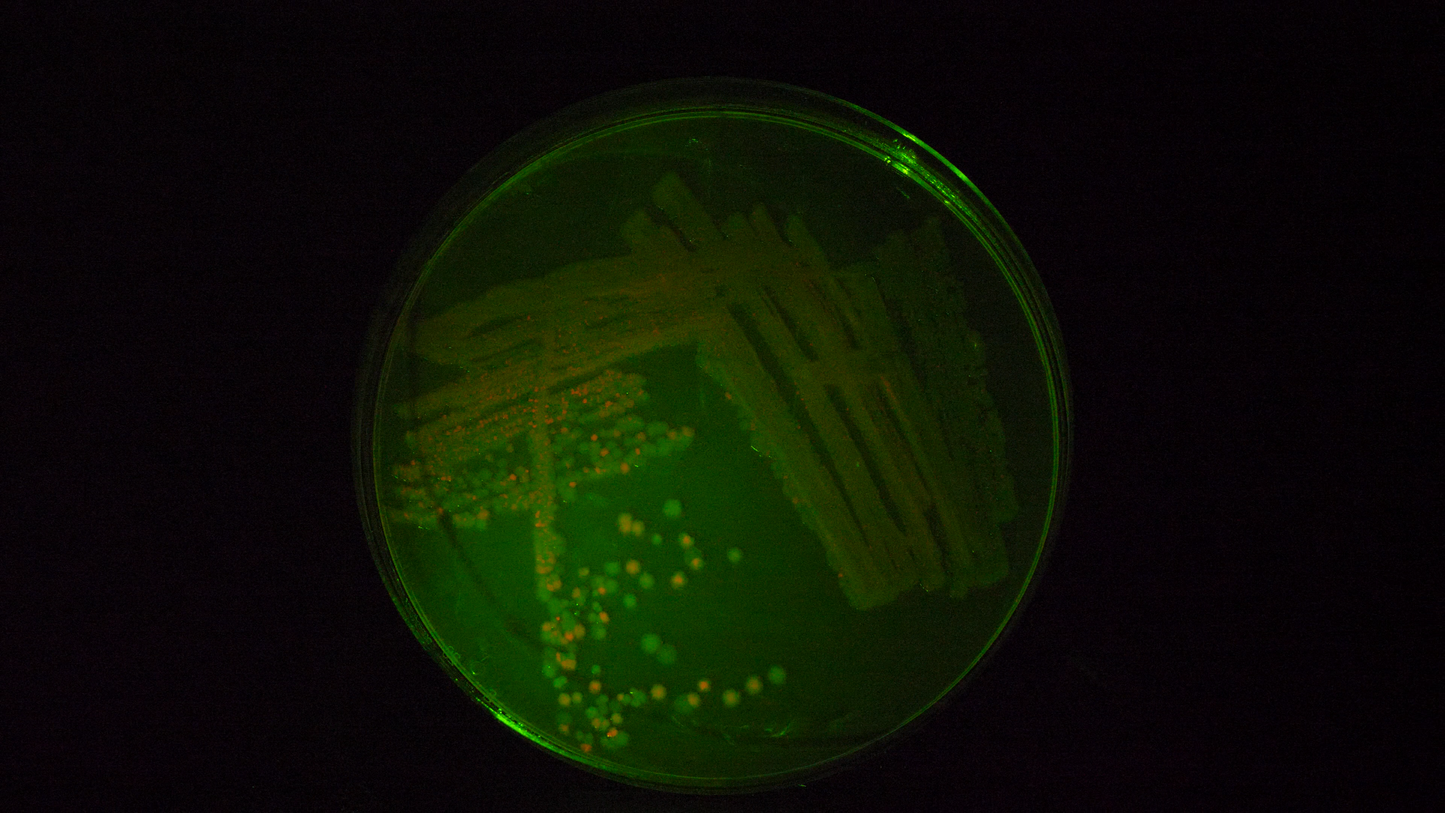

The Thought Emporium
Repressilator v1 | Plasmid
Repressilator v1 | Plasmid
Couldn't load pickup availability
This plasmid is our take on a classic and is a demonstration of a transistor-like oscillation circuit. It uses 3 repressor proteins wired in a loop to create a continuous oscillation inside living bacteria, effectively forming a clock. There are 3 reporter proteins so you can see what state the clock is in at any moment.
Two of the repressors are chemically triggerable, so you can shift what the oscillations do by streaking the bacteria onto plates that contain either lactose or anhydrotetracycline.
This plasmid is what we’re calling our “base” clock speed. The various colonies on a plate of this construct will glow different colors and may even display a ring structure as the clock ticks in each colony.
We are planning to release a faster clock that enhances the ring effect at a later date.
The plasmid is based on pet9a, and as such uses kanamycin as the resistance marker, and is low copy. As such it requires transformation into E. coli to work. The DNA is provided as 10ug of freeze dried DNA and must be shipped express. Freeze and store at -20C on receipt.
Plasmid maps can be found on our github: HERE
These constructs are provided as open source for you to modify and use as you please. Though we do ask for attribution, and no direct commercial resale.
Share